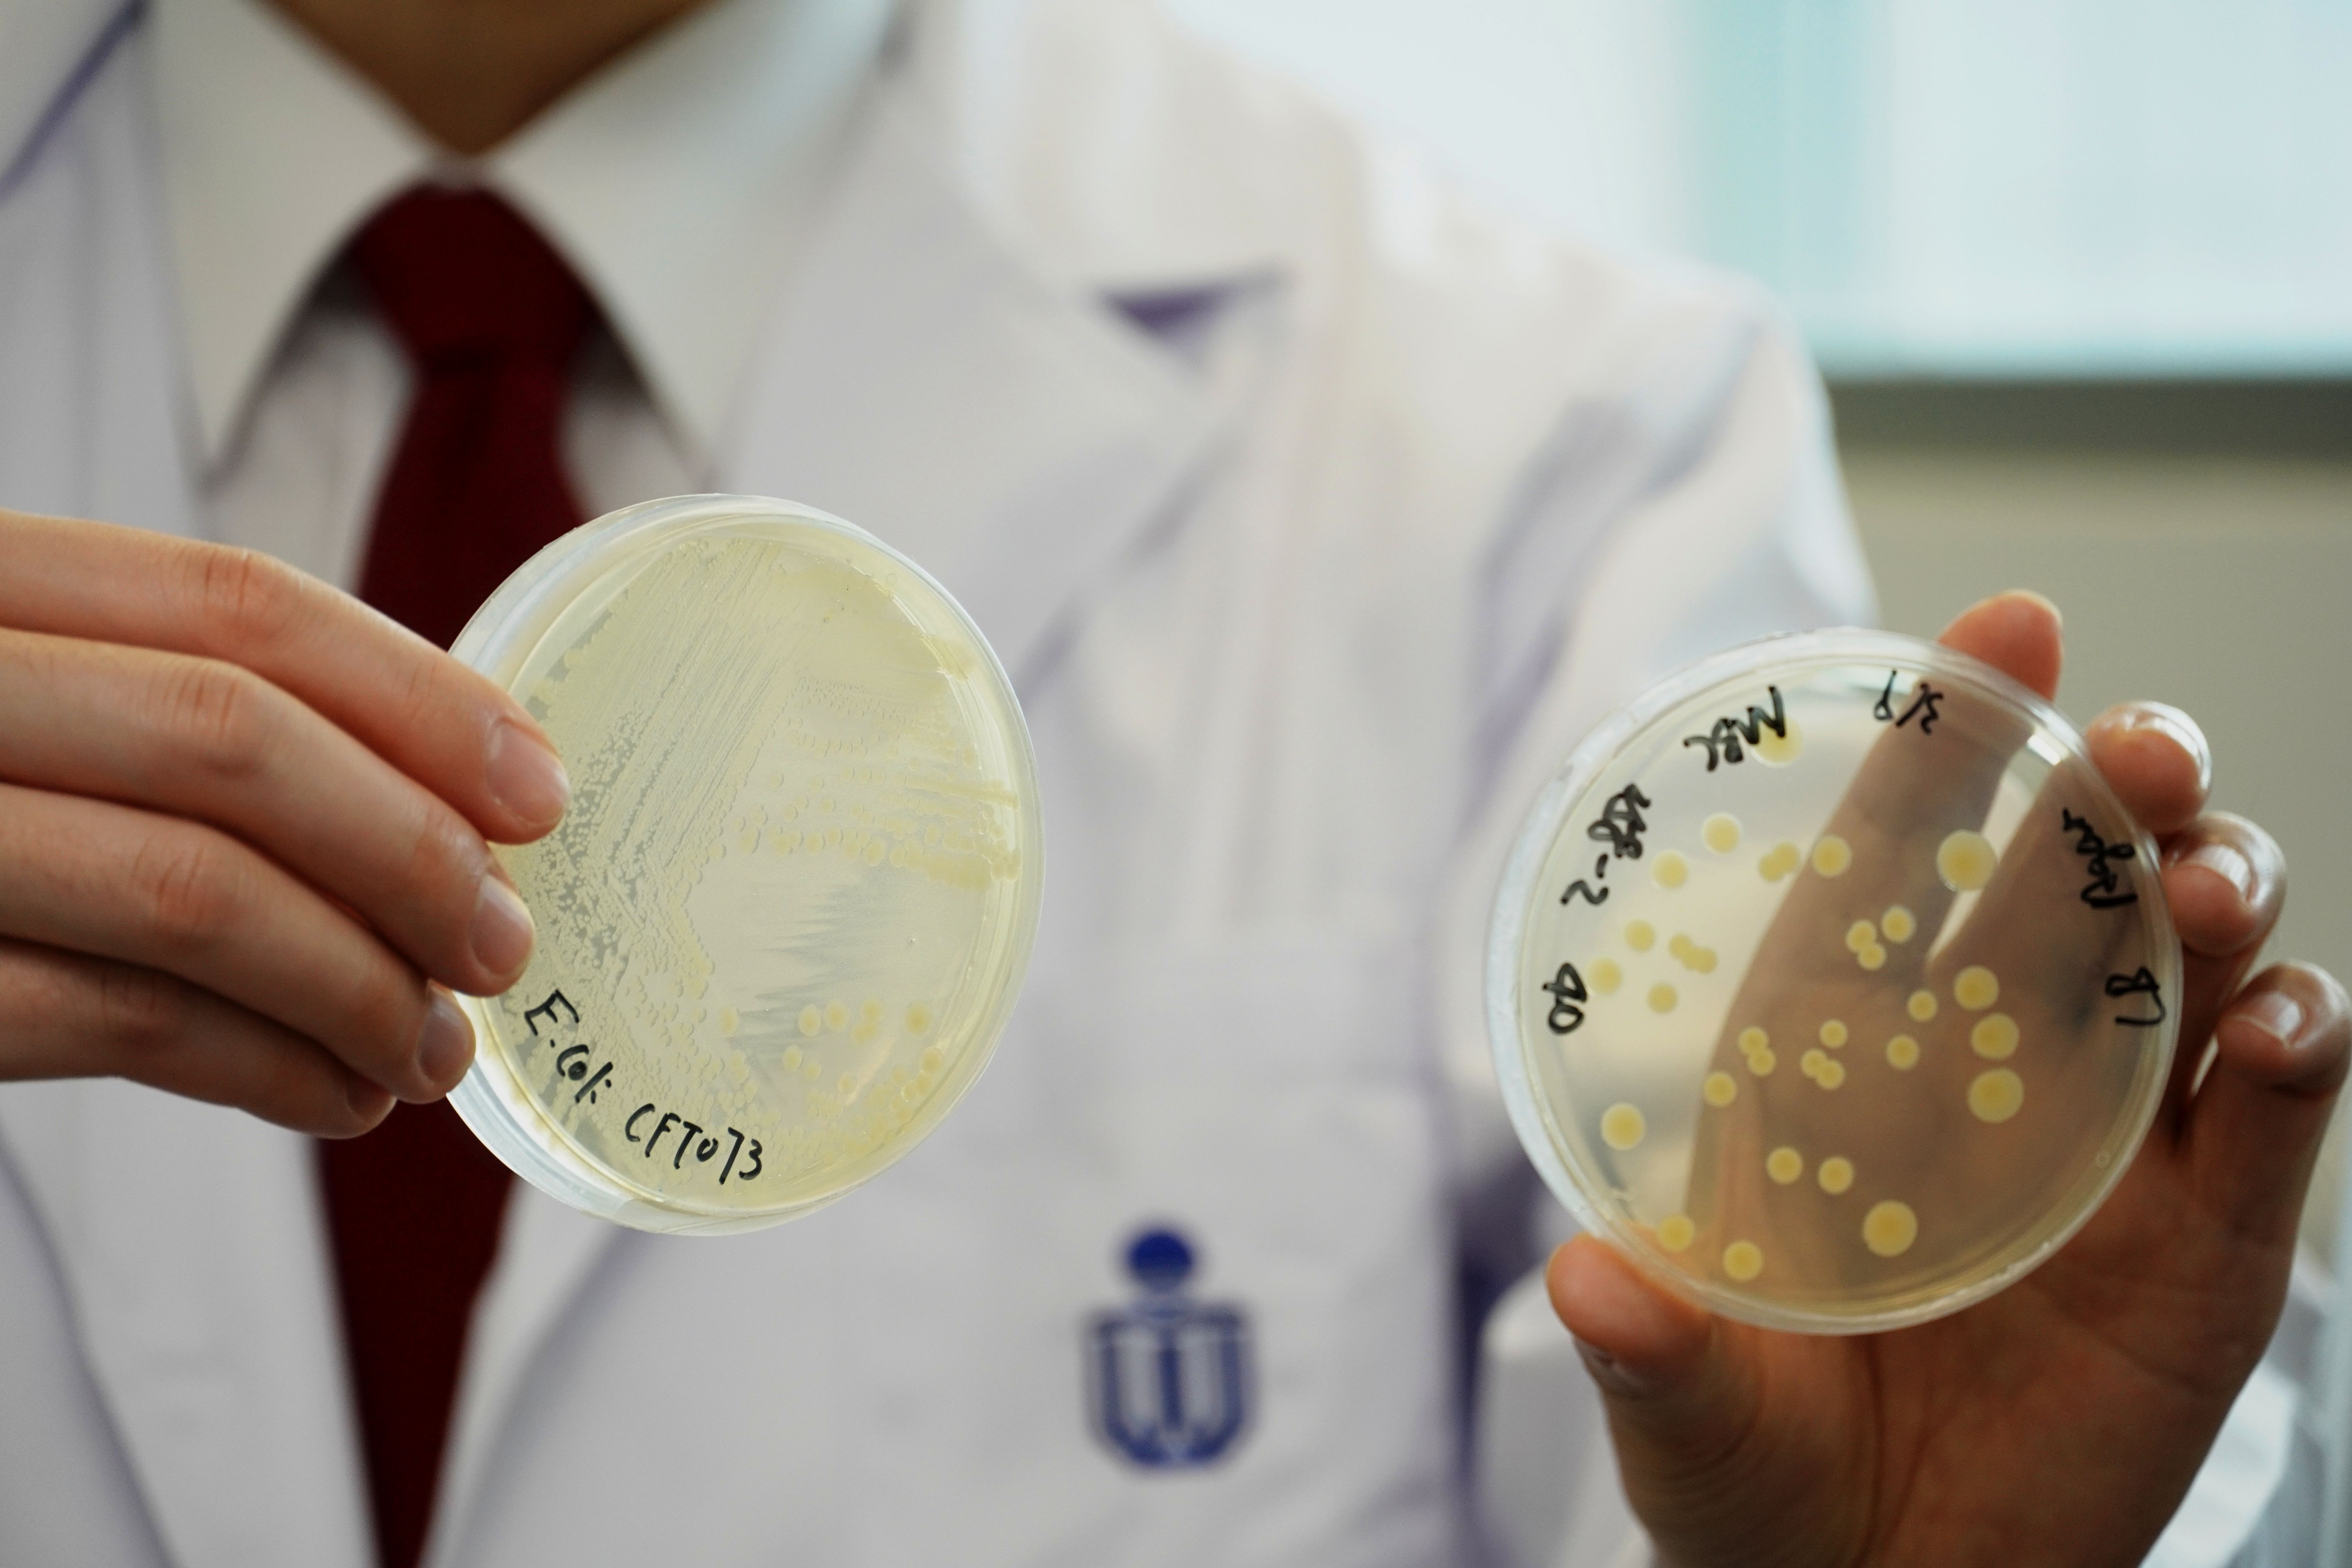
The dish on the left is the E. Coli cloned by the research team

HKUST Researchers Unlock Cancer-Causing Mechanism of E. coli Toxin with Synthetic Biology Approach Paving Way for New Preventive Measures for Colorectal Cancer
An inter-disciplinary team of researchers at the Hong Kong University of Science and Technology (HKUST) unraveled how a toxin released by Escherichia coli (E. coli) – a human gut bacteria, is connected to colorectal cancer, offering new insights to the health impact of this prevalent bacteria and facilitating future research on the prevention of this third most common cancer worldwide*.
While human gut microbes like E. coli help digest food and regulate our immune system, they also contain toxins that could arrest cell cycle and eventually cause cell death. Scientists have long known that colibactin – a genotoxin produced by E. coli, can induce DNA double-strand breaks in eukaryotic cells and increase the risk of colorectal cancer in human. However, how colibactin causes DNA damage had remained a mystery as reconstructing colibactin metabolites is extremely difficult due to the compound’s instability, low titer and complexity of its biosynthetic pathway.
Now, a research team led by Prof. Qian Peiyuan, David von Hansemann Professor of Science and Chair Professor of HKUST’s Department of Ocean Science and Division of Life Science, have unearthed the missing link using a novel biosynthetic method. The team not only succeeded in cloning the colibactin gene cluster, but also found a way to mass produce the genes for testing and validation. After repeated assays of various sets of colibactin precursors, the team eventually identified colibactin-645 as the culprit of the DNA double-strand breaks, and uncovered colibactin metabolite's biosynthetic pathway as well as its mechanism of causing DNA damage.
Prof. Qian said, “Although a few colibactin metabolites have been reported to damage DNA via DNA crosslinking activity, the genotoxic colibactin that possesses DNA double-strands directly is yet-to-be-identified. Our research has confirmed colibactin-645 exerts direct DNA double-strand breaks, that unearthed the missing link that correlates colibactin to its health effects on human beings.”
LI Zhongrui, a researcher of the team, said the restructuring of colibactin’s molecular scaffold provides a model for designing and synthesizing potent DNA cleaving agents – such as synthetic restriction “enzymes” or chemotherapeutic agents.
In collaboration with University of California at Berkeley and Scripps Institution of Oceanography of University of California, San Diego, the research findings were recently published in the prestigious scientific journal Nature Chemistry and the early findings on colibactin were published in another scientific journal Nature Chemical Biology.
*According to the statistics of World Cancer Research Fund 2018: https://www.wcrf.org/dietandcancer/cancer-trends/colorectal-cancer-statistics
About The Hong Kong University of Science and Technology
The Hong Kong University of Science and Technology (HKUST) (www.ust.hk) is a world-class research university that focuses on science, technology and business as well as humanities and social science. HKUST offers an international campus, and a holistic and interdisciplinary pedagogy to nurture well-rounded graduates with global vision, a strong entrepreneurial spirit and innovative thinking. HKUST attained the highest proportion of internationally excellent research work in the Research Assessment Exercise 2014 of Hong Kong’s University Grants Committee, and is ranked as the world’s best young university in Times Higher Education’s Young University Rankings 2019. Its graduates were ranked 16th worldwide and top in Greater China in Global Employability University Survey 2018.
For media enquiries, please contact:
Anita Lam
Tel: 2358 6313
Email: anitalam@ust.hk
Lindy Wong
Tel: 2358 6306
Email: lindywong@ust.hk